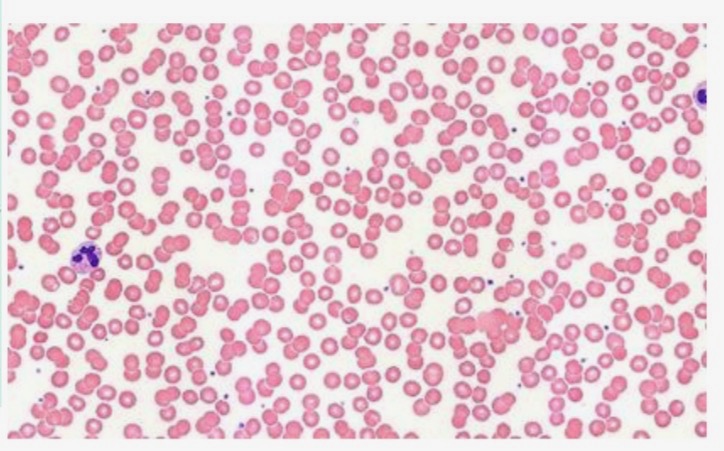
<p>Normal Blood of healthy male</p>
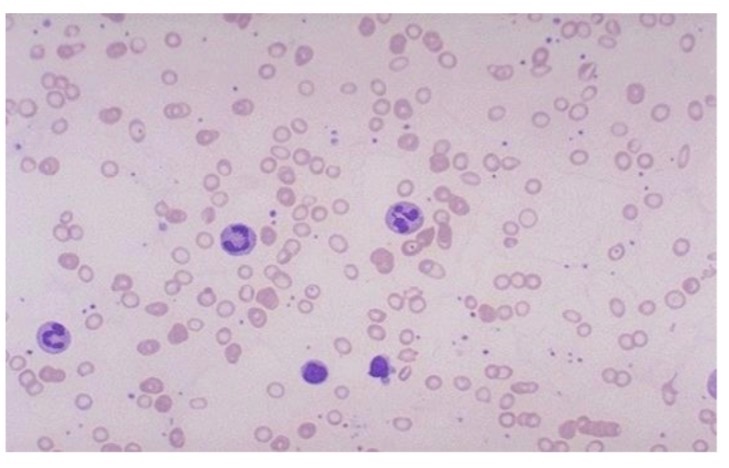
<p>Low iron anemia in male who is cold, pale, and fatigued </p>
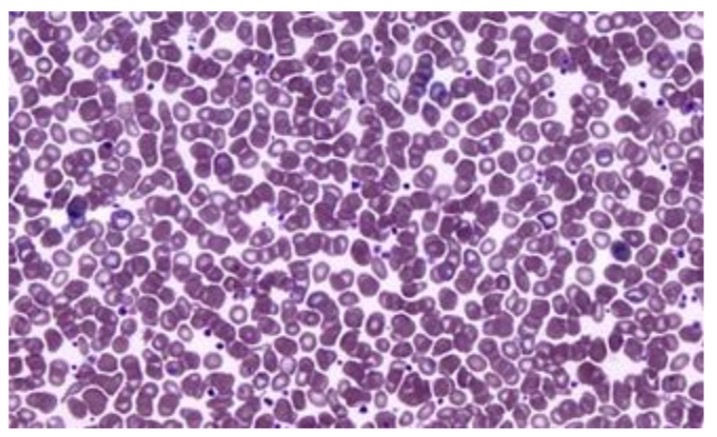
<p>Polycythemia of a male </p>

lab 8 quiz on lab 7
1/83
There's no tags or description
Looks like no tags are added yet.
Name | Mastery | Learn | Test | Matching | Spaced | Call with Kai |
|---|
No analytics yet
Send a link to your students to track their progress
84 Terms
Pulmonary ventilation
Air moves in and out of lungs
Alveolar respiration
Gas exchange between lungs and blood
Tissue respiration
Gas exchange between blood and tissues
Cellular respiration
Cells use O₂ to make energy (mitochondria)
Is it air movement?
→ ventilation
Is it lungs ↔ blood?
→ alveolar
Is it blood ↔ tissues?
→ tissue
Is it inside cells?
→ cellular
Pulmonary ventilation problems (air can’t move)
Choking
Asthma (bronchospasm)
Spinal cord injury (diaphragm stops)
Swollen tongue (anaphylaxis)
Alveolar respiration problems (lungs ↔ blood issue)
Pneumonia (fluid in alveoli)
Emphysema (damaged alveoli)
Pulmonary embolism
Tissue respiration problems (blood ↔ tissue issue)
Blocked arteries
Poor blood flow
Infarction (dead tissue)
Cellular respiration problems (mitochondria issue)
Cyanide poisoning
Missing enzymes (CoQ10)
Genetic mitochondrial disorder
PULMONARY FUNCTION TESTS:
What they measure:
Lung volume
Airflow
Gas exchange
PULMONARY FUNCTION TESTS:
Obstructive disease
→ Hard to get air OUT (elasticity issue)
PULMONARY FUNCTION TESTS:
Obstructive disease examples
Asthma
COPD
emphysema
PULMONARY FUNCTION TESTS:
Obstructive diseases key idea
Air trapped
PULMONARY FUNCTION TESTS:
Restrictive disease
→ Lungs can’t expand
PULMONARY FUNCTION TESTS:
Restrictive disease examples
Fibrosis
Pneumonia
Chest wall issues (scoliosis)
PULMONARY FUNCTION TESTS:
Restrictive diseases key idea
Low lung volume
SPIROMETRY VALUES:
TV (tidal volume)
Normal breaths
SPIROMETRY VALUES:
IRV (Inspiratory Reserve Volume)
Extra inhale
SPIROMETRY VALUES:
ERV (Expiratory Reserve Volume)
Extra exhale
SPIROMETRY VALUES:
RV (Residual Volume)
Air left in lungs (cannot remove)
SPIROMETRY FORMULAS:
Vital Capacity?
TV + IRV + ERV
SPIROMETRY FORMULAS:
Total Lung Capacity?
VC + RV
Forced values?
FVC and FEV1
FVC
forced exhale
FEV1
air out in 1 second
KEY TEST RATIO?
FEV1 / FVC
OBSTRUCTIVE:
“signs”
FEV1 ↓↓↓
FVC normal/slightly ↓
Ratio ↓
RESTRICTIVE:
“signs”
FEV1 ↓
FVC ↓↓↓
Ratio normal or ↑
Minute Ventilation Formula
TV × RR
Alveolar Ventilation formula:
(TV − 0.15) × RR
Alveolar Ventilation (AVR) = 0.15
dead space
PULSE OXIMETRY
noninvasive, painless test that measures the percentage of oxygen saturation in the blood (SpO₂) and heart rate
SpO₂ measures?
% of hemoglobin with oxygen
SpO₂ normal values
95–100%
SpO₂ ok values
90%
SpO₂ dangerous values
≤88%
PULSE OXIMETRY:
Cause of
If no pulse detected → reading = 0
(even if heart is beating)
Poor blood flow
Shock
Vasoconstriction
HEMOGLOBIN Structure:
4 subunits
4 iron (Fe)
Each Hb carries 4 O₂
Deoxygenated HEMOGLOBIN
no O₂ attached
Oxygenated HEMOGLOBIN
O₂ attached
What does O₂ actually bind to
iron (Fe)
CO₂ transport:
Binds to protein part → carbaminoHb
BLOOD VALUES:
WBC
5,000–10,000
BLOOD VALUES:
RBC
4.8-5.4 million
BLOOD VALUES:
Platelets
150k–400k
BLOOD VALUES:
O₂ saturation
95–100%
STEP 1: Look at FVC
FVC ≥ 80%
NOT restrictive
STEP 1: Look at FVC
FVC < 80%
could be restrictive
STEP 2: If NOT restrictive → check ratio
FEV1/FVC ≥ 0.7
Normal
STEP 2: If NOT restrictive → check ratio
FEV1/FVC < 0.7
OBSTRUCTIVE
STEP 3: If FVC < 80 → check TLC
TLC ≥ 80
obstructive
STEP 3: If FVC < 80 → check TLC
TLC < 80
restrictive
Low ratio
OBSTRUCTIVE
Low volume
RESTRICTIVE
VC PERCENT formula:
(measured VC / expected VC) × 100
VC PERCENT Interpretation:
80–120%
NORMAL
VC PERCENT Interpretation:
<80%
weak lungs
VC PERCENT Interpretation:
>120%
strong lungs
PLEURAL / LUNG CONDITIONS:
Pneumothorax
air in chest → lung collapses
PLEURAL / LUNG CONDITIONS:
Pleural effusion
fluid → lung collapses
PLEURAL / LUNG CONDITIONS:
Hemothorax
blood in chest → lung collapses
PLEURAL / LUNG CONDITIONS:
Atelectasis
collapsed alveoli
OXIMETRY Values:
95–100%
normal
OXIMETRY Values:
<90%
bad
OXIMETRY Values:
<88%
emergency
CARBON MONOXIDE key signs
“cherry red lips”
“false 100%”
Reason for CARBON MONOXIDE signs
CO binds stronger than O₂ → pulse ox reads normal
Patient looks oxygenated
But actually dying
Methemoglobin
iron in red blood cells is oxidized to 𝐹𝑒3+, preventing oxygen release to tissues
Sulfhemoglobin
a rare condition where sulfur binds to hemoglobin, creating a stable, green-pigmented molecule that cannot transport oxygen.
Peripheral pulse
from wrist
Pulse
pressure wave from heart
Normal Blood of healthy male
CaO2 = 20.4mL/dL
Hb = 15
Low iron anemia in male who is cold, pale, and fatigued
CaO2 = 13.7mL/dL
Hb = 10
Polycythemia of a male
CaO2 = 40.5mL/dL
Hb = 30

covid

Restrictive

Obstructive
Blood Hb in males
12-17g/dL
Blood Hb in females
11-16g/dL

Atelectasis and Pleural Effusion

Hemothorax